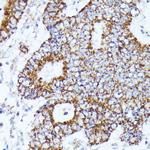
AKR1C2 Antibody in Immunohistochemistry (Paraffin) (IHC (P))
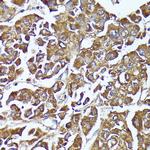
AKR1C2 Antibody in Immunohistochemistry (Paraffin) (IHC (P))

Search
Invitrogen
AKR1C2 Polyclonal Antibody
{{$productOrderCtrl.translations['antibody.pdp.commerceCard.promotion.promotions']}}
{{$productOrderCtrl.translations['antibody.pdp.commerceCard.promotion.viewpromo']}}
{{$productOrderCtrl.translations['antibody.pdp.commerceCard.promotion.promocode']}}: {{promo.promoCode}} {{promo.promoTitle}} {{promo.promoDescription}}. {{$productOrderCtrl.translations['antibody.pdp.commerceCard.promotion.learnmore']}}

Please note: We are reviewing Western blot images included in the antibody testing data in our catalog, including those provided by third parties. Unless expressly labeled or annotated as “raw-unedited”, Western blot images included in the antibody testing data in our catalog may have been edited, optimized or otherwise adjusted for presentation.
产品信息
PA5-87930
种属反应
宿主/亚型
分类
类型
抗原
偶联物
形式
浓度
规格
纯化类型
保存液
内含物
保存条件
运输条件
RRID
产品详细信息
Immunogen sequence: MDSKYQCVKL NDGHFMPVLG FGTYAPAEVP KSKALEAVKL AIEAGFHHID SAHVYNNEEQ VGLAIRSKIA DGSVKREDIF YTSKLWSNSH RPELVRPALE RSLKNLQLDY VDLYLIHFPV SVKPGEEVIP KDENGKILFD TVDLCATWEA MEKCKDAGLA KSIGVSNFNH RLLEMILNKP GLKYKPVCNQ VECHPYFNQR KLLDFCKSKD IVLVAYSALG SHREEPWVDP NSPVLLEDPV LCALAKKHKR TPALIALRYQ LQRGVVVLAK SYNEQRIRQN VQVFEFQLTS EEMKAIDGLN RNVRYLTLDI FAGPPNYPFS DEY; Positive Samples: HT-29, A549, Mouse liver; Cellular Location: Cytoplasm
靶标信息
DD1 is also designated AKR1C1, DDH or DDH1, while DD2 also can be designated AKR1C2, dDD, BABP or DDH2. AKR1C3 and 3 alpha-HSD are alternate designations for human DD3 (which is referred to as AKR1C18 in rodents), while DD4 also can be called AKR1C4, CD, CHDR or AKR1C6 (in rodents). DD1 and DD2 are 20 alpha-HSDs, whereas DD3 and DD4 are the 3 alpha- HSDs. The multiple human cytosolic dihydrodiol dehydrogenases are involved in the metabolism of xenobiotics, such as polycyclic aromatic hydrocarbons, pesticides and steroid hormones, and are responsible for the reduction of ketone-containing drugs by using NADH or NADPH as a cofactor. The 20 alpha- HSD catalyzes the reaction of Progesterone to the inactive form 20 alpha-hydroxyprogesterone.
仅用于科研。不用于诊断过程。未经明确授权不得转售。
篇参考文献 (0)
生物信息学
蛋白别名: 17-alpha-HSD; 17-alpha-hydroxysteroid dehydrogenase; 3 alpha-HSD3; 3(17)alpha-hydroxysteroid dehydrogenase; 3(or 17)-alpha-hydroxysteroid dehydrogenase; 3-alpha-HSD3; 3-alpha-hydroxysteroid dehydrogenase; Aldo-keto reductase family 1 member C2; Aldo-keto reductase family 1 member C21; aldo-keto reductase family 1, member C21; chlordecone reductase homolog; Chlordecone reductase homolog HAKRD; DD-2; DD/BABP; DD1; DD3; Dihydrodiol dehydrogenase 2; dihydrodiol dehydrogenase 2; bile acid binding protein; 3-alpha hydroxysteroid dehydrogenase, type III; Dihydrodiol dehydrogenase type 1; Dihydrodiol dehydrogenase type 3; Dihydrodiol dehydrogenase/bile acid-binding protein; HSD3-3 alpha; HSD3-alpha3; pseudo-chlordecone reductase; testicular 17,20-desmolase deficiency; trans-1,2-dihydrobenzene-1,2-diol dehydrogenase; type II dihydrodiol dehydrogenase; Type III 3-alpha-hydroxysteroid dehydrogenase; unnamed protein product
基因别名: 9430025F20Rik; AI315367; AKR1C-pseudo; AKR1C2; Akr1c21; BABP; DD; DD-2; DD/BABP; DD2; DDH2; HAKRD; HBAB; MCDR2; SRXY8; TDD
UniProt ID: (Rat) Q6AYQ2, (Mouse) Q91WR5
Entrez Gene ID: (Human) 1646, (Rat) 291283, (Mouse) 77337




